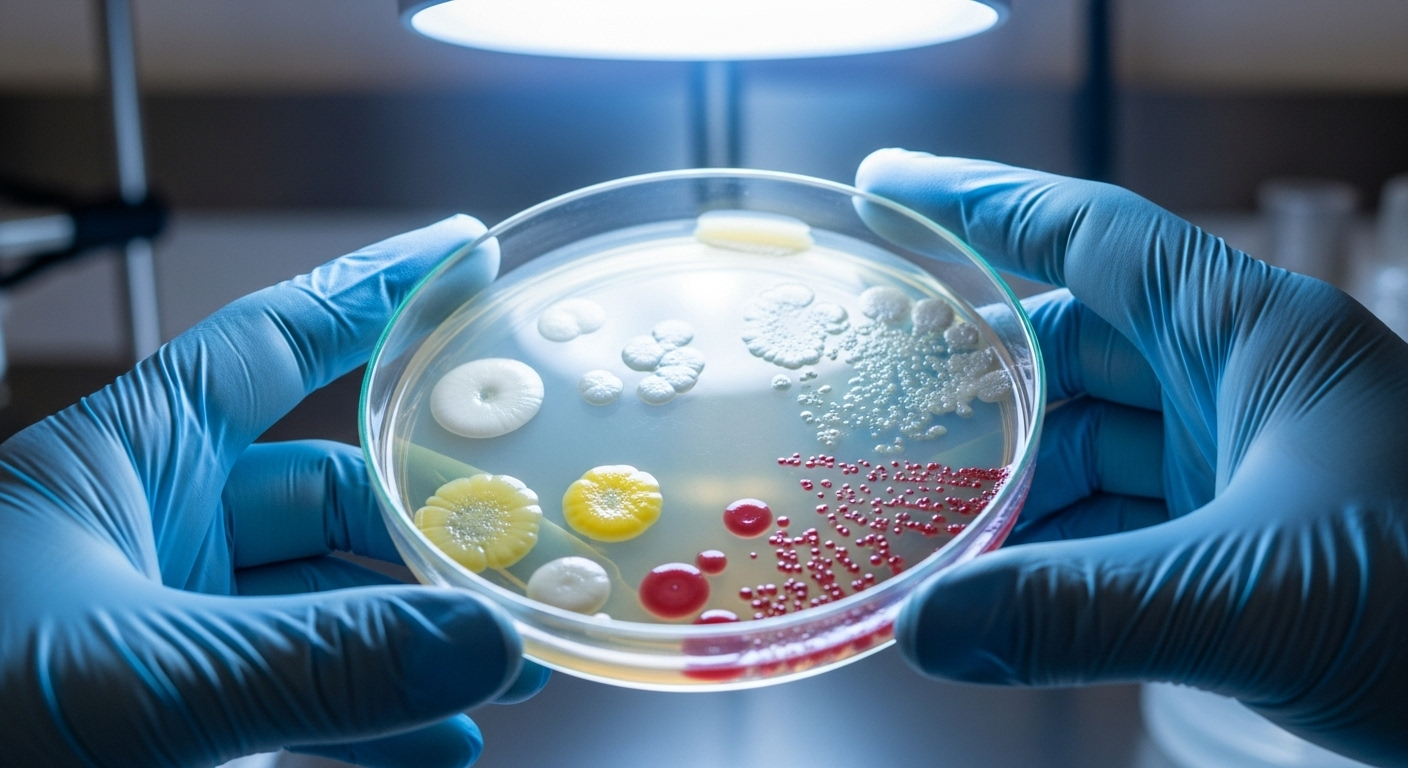
Le coupable est une bactérie bien connue

Imaginez un mystère qui pèse sur nos océans depuis plus de dix ans. Une véritable hécatombe qui a décimé des milliards d’étoiles de mer sans que personne ne comprenne pourquoi. Eh bien, des scientifiques viennent enfin de percer le secret. C’est une nouvelle qui apporte un immense soulagement et, surtout, un nouvel espoir pour la vie sous-marine.
Depuis 2013, une maladie étrange transformait ces magnifiques créatures en une sorte de bouillie, laissant les fonds marins déserts. Aujourd’hui, on sait enfin qui est le coupable.
Une hécatombe sur les côtes du pacifique

Tout a commencé en 2013. Une maladie mystérieuse, baptisée « maladie du dépérissement de l’étoile de mer », a commencé à faire des ravages. C’était un massacre silencieux, qui s’est étendu sur des milliers de kilomètres de côtes, depuis le Mexique jusqu’en Alaska.
Au total, on estime que plus de 5 milliards d’étoiles de mer de plus de 20 espèces différentes ont péri. C’est un chiffre qui donne le vertige. L’épidémie n’est d’ailleurs pas totalement terminée, même si le pire semble être passé.
L'étoile tournesol, principale victime de la maladie

Parmi toutes les victimes, une espèce a payé un tribut particulièrement lourd : l’étoile de mer tournesol. C’est une créature impressionnante, qui peut avoir jusqu’à 24 bras et se pare de couleurs magnifiques. Malheureusement, elle a été la plus touchée.
Les chiffres sont terribles : en seulement cinq ans, environ 90% de sa population a été anéantie. Elle a pratiquement disparu de certaines zones où elle était autrefois abondante. Une perte immense pour la biodiversité de l’océan.
Des symptômes qui font froid dans le dos

Les scientifiques décrivent le spectacle comme étant « vraiment horrible ». Une étoile de mer en bonne santé a des bras bien droits, comme gonflés. Mais avec cette maladie, des taches blanches, des lésions, apparaissent sur leur corps.
Ensuite, c’est la catastrophe : leurs bras se ramollissent et finissent littéralement par tomber un par un. L’animal se désintègre sur place. Difficile d’imaginer une fin plus triste pour ces créatures qui embellissent nos fonds marins.
Le coupable est une bactérie bien connue
Après des années de recherches et de fausses pistes, le coupable a enfin été démasqué. Ce n’est pas un virus, comme on l’a longtemps cru, mais une bactérie. Son nom : la bactérie *Vibrio pectenicida*.
Ce qui est intéressant, c’est que cette bactérie n’est pas une inconnue. On la retrouve aussi chez certains coquillages. Il aura fallu du temps pour la pointer du doigt, mais cette fois, les chercheurs en sont certains.
Une enquête digne d'un roman policier

Identifier cette bactérie a été un véritable travail de détective. Au début, tout le monde pensait à un virus, mais cette piste n’a rien donné. Le vrai coupable passait entre les mailles du filet.
La clé du mystère a été trouvée en changeant de méthode. Au lieu d’analyser uniquement les tissus des étoiles mortes, les chercheurs ont eu l’idée d’étudier le liquide qui baigne leurs organes, qu’on appelle le fluide cœlomique. C’est là, dans ce liquide, qu’ils ont trouvé la bactérie en grande quantité. Une preuve irréfutable après une décennie d’efforts.
Pourquoi est-ce si important ? l'effet domino

On pourrait se dire : « c’est triste pour les étoiles de mer, mais en quoi cela nous concerne ? » En réalité, leur disparition a provoqué un véritable effet domino. Les étoiles de mer, surtout les tournesols, sont de grandes prédatrices d’oursins.
Sans elles pour les manger, la population d’oursins a explosé. Et ces oursins affamés se sont jetés sur leur plat préféré : les forêts de varech, ces grandes algues qui forment des abris vitaux pour des centaines d’espèces. Résultat, dans certaines régions comme la Californie du Nord, 95% de ces forêts sous-marines ont été dévorées. C’est comme si on rasait nos forêts sur terre. Un désastre écologique.
Et maintenant ? l'espoir renaît pour les étoiles de mer

Maintenant que l’on connaît l’ennemi, on peut enfin commencer à se battre. Les scientifiques ont plusieurs idées. Ils peuvent tester les étoiles de mer survivantes pour voir si certaines ont une immunité naturelle. Si c’est le cas, on pourrait les élever en captivité pour ensuite les réintroduire dans la nature.
On pourrait aussi les déplacer vers des zones plus sûres ou même tester des traitements, comme des probiotiques, pour renforcer leurs défenses. L’espoir est de pouvoir un jour restaurer les populations d’étoiles de mer et, par la même occasion, de voir renaître les magnifiques forêts de varech.
Conclusion : Une lueur d'espoir pour les forêts sous-marines

Cette découverte est bien plus qu’une simple publication scientifique. C’est une porte qui s’ouvre sur l’avenir. Connaître la cause de cette maladie est la première étape essentielle pour pouvoir agir. Ce n’est pas seulement l’avenir des étoiles de mer qui est en jeu, mais celui de tout un écosystème côtier qui dépend d’elles.
Le chemin sera long, bien sûr, mais pour la première fois en dix ans, il y a une vraie raison d’être optimiste. On peut enfin espérer revoir un jour les « forêts tropicales de l’océan » retrouver leur splendeur d’antan.
Selon la source : pbs.org










